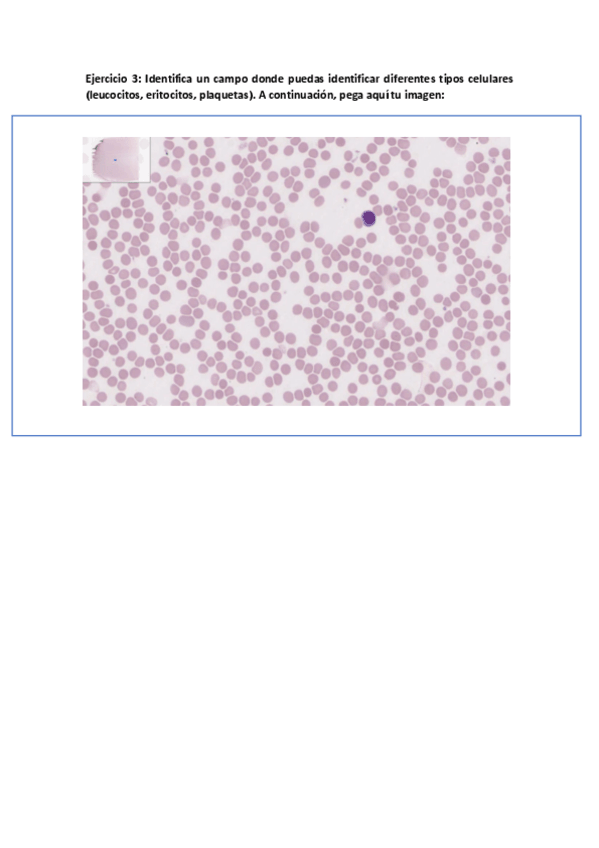

Biología
apuntes
-
BLOQUE BIOQUIMICA
APUNTES RESUMIDOS BLOQUE BIOQUIMICA DE BIOLOGIA 1º LOGOPEDIA UVA
practicas
-
Prácticas Laboratorio Biología
Algunas de las prácticas hechas en el laboratorio. Algunas pueden caer en el examen
apuntes
-
Biología - Histología
Apuntes del tema 12 al 15 de histología, son bastante extensos y vienen con explicaciones extra para entenderlo todo
apuntes
-
Biología - Biología Celular
Apuntes del tema 1 al 11 de Biología Celular en el curso 2025/26 junto a explicaciones extra para entenderlo
Cuestionario tipo test tras haber visto los temas a hacer en el campus en casa
Cuestionario tipo test tras haber visto los temas a hacer en el campus en casa
Cuestionario tipo test tras haber visto los temas a hacer en el campus en casa
apuntes
-
Biología - Bioquímica
Los apuntes de los 7 primeros temas de bioquímica + información adicional para entenderlo
He publicado nuevos apuntes de 1º Biología: CUADRANTES-ABDOMINALES.docx
He publicado nuevos practicas de 1º Biología: Practica-6.-Tejido-conectivo-especializado-tejido-muscular-y-tejido-nervioso.pdf
He publicado nuevos practicas de 1º Biología: Practica-5.-Tejido-epitelial-y-tejido-conectivo-propiamente-dicho..pdf
He publicado nuevos practicas de 1º Biología: PRACTICA-4.-Nucleo.-Gametogenesis.pdf
He publicado nuevos practicas de 1º Biología: PRACTICA-3.-Inclusiones-citoplasmaticas.-Ribosomas.-RE.-AG.-Lisosomas.-Peroxisomas.-Mitocondrias.pdf
He publicado nuevos practicas de 1º Biología: PRACTICA-2.-Superficie-celular.-Uniones-celulares.-Citoesqueleto.pdf
He publicado nuevos practicas de 1º Biología: PRACTICA-1.-Microscopia.-Procariotas.-Eucariotas.Virus.pdf
He publicado nuevos otros de 1º Biología: Ejercicios-sin-respuestas-logopedia-2023.pdf
alguien tiene un modelo de examen de biologia
He publicado nuevos practicas de 1º Biología: Practicas-de-laboratorio.pdf
@Anónimo
apuntes
-
1º Logopedia - Biología
He publicado nuevos apuntes de 1º Biología: 1º Logopedia - Biología
@Anónimo
He publicado nuevos apuntes de 1º Biología: TEMA-4-CITOESQUELETO.pdf
@Anónimo
He publicado nuevos apuntes de 1º Biología: TEMA-2-MEMBRANA-PLASMATICA-Y-GLUCOCALIX.pdf
@Anónimo
He publicado nuevos apuntes de 1º Biología: TEMA-3-ESPECIALIZACIONES-DE-MEMBRANA-Y-UNIONES-INTERCELULARES.pdf
@Anónimo
He publicado nuevos apuntes de 1º Biología: TEMA-1-ORGANIZACION-DE-LOS-SERES-VIVOS-METODOS-Y-TECNICAS-BASICAS.pdf
@Anónimo
He publicado nuevos apuntes de 1º Biología: TEMA-6-RETICULO-ENDOPLASMATICO-APARATO-DE-GOLGI.pdf
@Anónimo
@Anónimo
He publicado nuevos apuntes de 1º Biología: TEMA-8-MITOCONDRIAS-INCLUSIONES-CITOPLASMATICAS.pdf
@Anónimo
He publicado nuevos apuntes de 1º Biología: TEMA-10-CICLO-CELULAR.-MITOSIS.-MUERTE-CELULAR.pdf
@Anónimo
@Anónimo
He publicado nuevos apuntes de 1º Biología: TEMA-11-MEIOSIS-Y-GAMETOGENESIS.pdf
@Anónimo
He publicado nuevos apuntes de 1º Biología: TEMA-7-TRANSPORTE-VESICULAR-LISOSOMAS-PEROXISOMAS.pdf
@Anónimo
He publicado nuevos apuntes de 1º Biología: TEMA-17-histologia-1.docx.pdf
@Anónimo
He publicado nuevos apuntes de 1º Biología: TEMA-16-TEJIDO-NERVIOSO.pdf
@Anónimo
He publicado nuevos apuntes de 1º Biología: TEMA-15-TEJIDO-MUSCULAR.pdf
@Anónimo
He publicado nuevos apuntes de 1º Biología: TEMA-14-TEJIDO-CONECTIVO-1.pdf
@Anónimo
He publicado nuevos apuntes de 1º Biología: TEMA-13-EPITELIO-GLANDULAR.pdf
He publicado nuevos apuntes de 1º Biología: TEMA-12-CONCEPTO-DE-TEJIDO-TEJIDO-EPITELIAL.pdf
apuntes
-
mediación comunicativa
FOl
He publicado nuevos apuntes de 1º Biología: Sistema-urinario-anatomia.pdf
He publicado nuevos apuntes de 1º Biología: Sistema-Digestivo-anatomia.pdf
He publicado nuevos apuntes de 1º Biología: Sistema-locomotor-Anatomia.pdf
He publicado nuevos apuntes de 1º Biología: Sistema-circulatorio-Anatomia.pdf
He publicado nuevos apuntes de 1º Biología: Introduccion-Bloque-III-BIOLOGIA-ANATOMIA.pdf
He publicado nuevos apuntes de 1º Biología: 18-APARATO-RESPIRATORIO.pdf
He publicado nuevos apuntes de 1º Biología: 15-TEJIDO-CONJUNTIVO.pdf
He publicado nuevos apuntes de 1º Biología: 13-REPRODUCCION-SEXUAL.pdf
He publicado nuevos apuntes de 1º Biología: 11-PEROXISOMAS-Y-MITOCONDRIA.pdf
He publicado nuevos apuntes de 1º Biología: 10-SISTEMA-DE-ENDOMEMBRANAS.pdf
He publicado nuevos apuntes de 1º Biología: 8-METODOLOGIA-DE-ESTUDIO-DE-LA-CELULA.pdf
He publicado nuevos apuntes de 1º Biología: 7-ORGANIZACION-DE-LOS-SERES-VIVOS.pdf
He publicado nuevos apuntes de 1º Biología: 5-Aminoacidos-y-proteinas.pdf